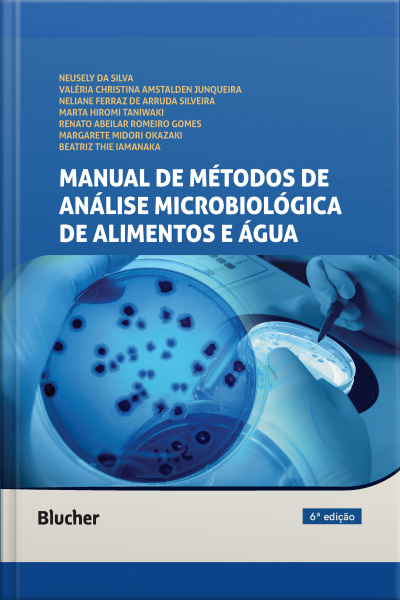
Manual De Métodos De Análise Microbiológica De Alimentos E Água

Manual De Métodos De Análise Microbiológica De Alimentos E Água
- Autor: Beatriz Thie Iamanaka
- Editor: Editora Blucher
Sinopsis
O Manual de métodos de análise microbiológica de alimentos e água é um manual de laboratório ilustrado contendo os métodos recomendados por órgãos internacionais (APHA, FDA, USDA, AOAC, ISO) aceitos pela Agência Nacional de Vigilância Sanitária (ANVISA).
Cada capítulo traz uma revisão profunda e atualizada sobre o(s) microrganismo(s) tratado(s), incluindo posição taxonômica, mudanças na nomenclatura, características morfológicas e bioquímicas e epidemiologia. Oferece também comparações esquemáticas entre os métodos disponíveis, destacando suas diferenças e similaridades. A apresentação didática do passo a passo dos métodos em figuras esquemáticas permite uma rápida apreensão dos procedimentos, facilitando sua execução no dia a dia dos laboratórios.